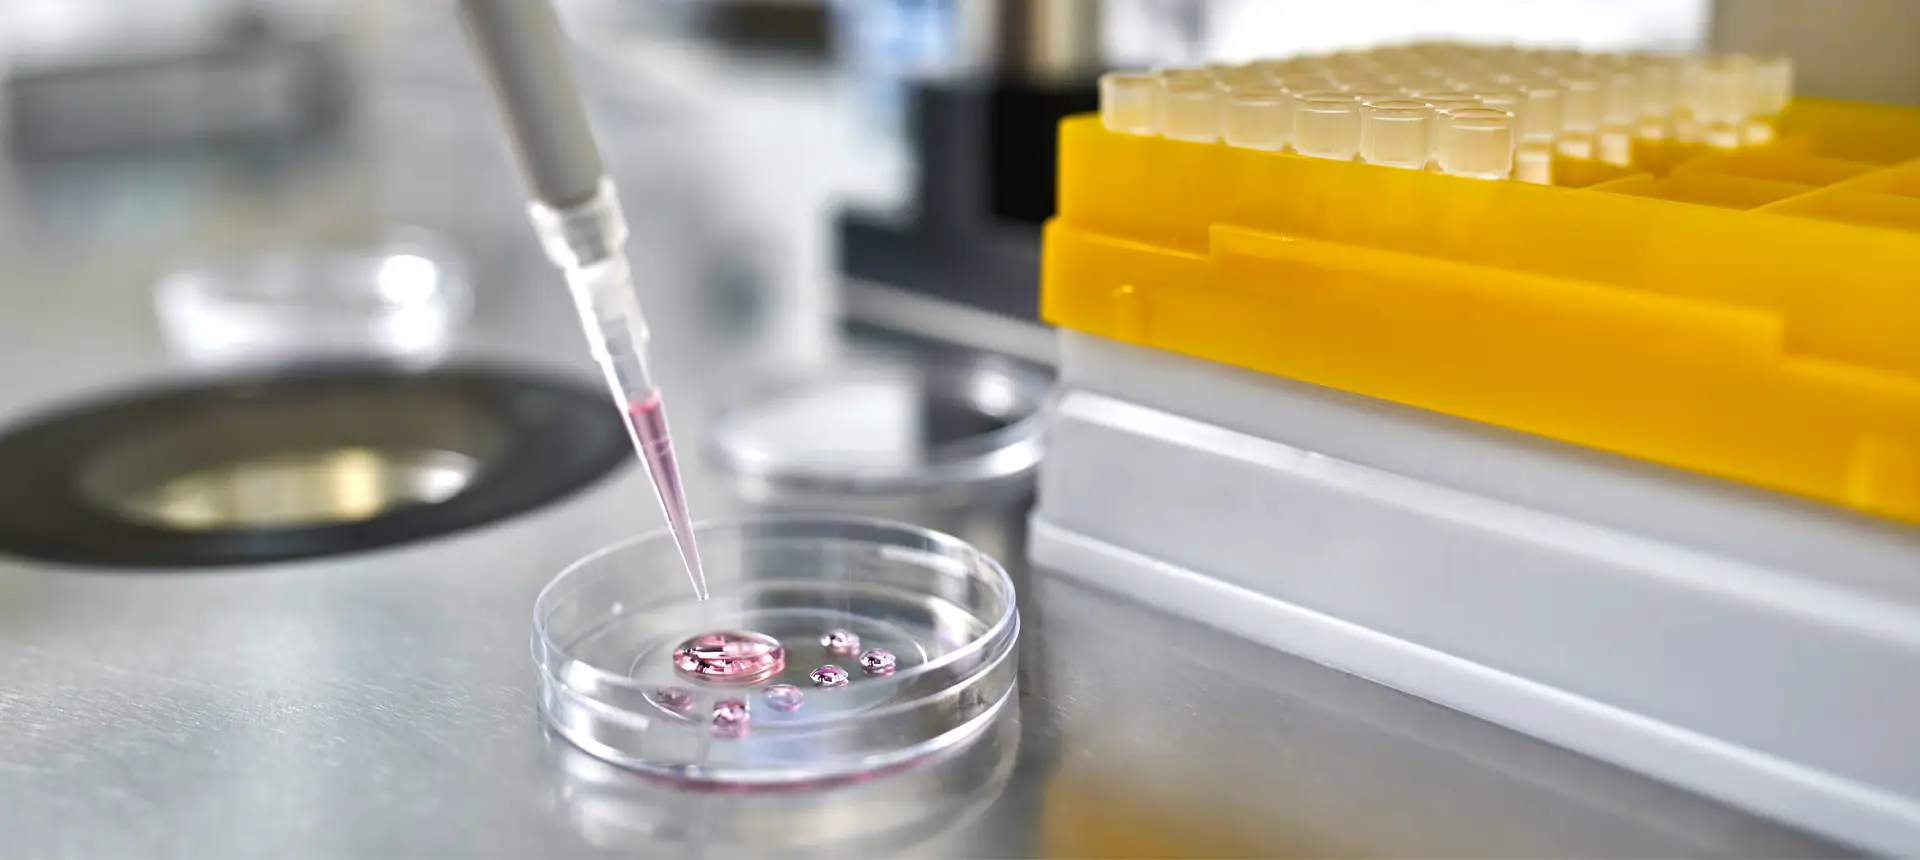
Processus de congélation des ovocytes par vitrification au centre IRIFIV Casablanca pour la préservation de la fertilité féminine

Nous sommes ici pour vous offrir des renseignements, des conseils, du soutien et de la compréhension.
Nous sommes ici pour vous offrir des renseignements, des conseils, du soutien et de la compréhension.

13, place du Nid d’Iris, Quartier Racine, Casablanca, 20000
PATIENTS INTERNATIONAUX
ARTICLES RÉCENTS
IRIFIV is a multidisciplinary fertility center in Casablanca, Morocco, specializing in IVF and ICSI. Since 1992, over 32 years of expertise and thousands of successful births demonstrate our commitment. We offer all techniques to evaluate and treat infertility with a personalized approach, multidisciplinary team, latest technology, complementary therapies, scientific research, teaching, professional development, and international collaboration.

Fondé en 1992, avec plus de 34 ans d’expérience et des milliers de bébés nés, IRIFIV Casablanca est le premier centre structuré marocain de procréation médicalement assistée et l’un des centres de fertilité et FIV les plus reconnus à Casablanca et au Maroc. La clinique est spécialisée dans tous les cas d’infertilité, y compris les cas complexes. Nous utilisons des technologies et équipements de dernière génération, dont certains uniques au Maroc. IRIFIV et le laboratoire Labomac constituent un terrain de stage pratique en FIV dans le cadre du Diplôme Universitaire de Biologie et Génétique de la Reproduction de l’Université Mohammed VI des Sciences de la Santé, et sont actifs en recherche, formation médicale et collaborations internationales.
© Copyright 2022 – | irifiv.com by Alforas Company, USA – email: info@alforasco.com | All Rights Reserved
© Copyright 2022 –| irifiv.com by Alforas Company, USA – email: info@alforasco.com | All Rights Reserved
choisissez ci-dessous l’option qui vous convient le plus, ou appelez-nous au:
Abstinence : 2 à 5 jours
Émission : au laboratoire
Méthode : selon l’OMS la masturbation est la méthode de référence, cependant l’émission à domicile est tolérée si l’acheminement a LABOMAC n’excède pas 30 minutes
Précautions : laver les mains et la verge à la savonnette neutre ou autre antiseptique équivalent
Mettre l’intégralité de l’émission dans le flacon fourni par LABOMAC
Veuillez contacter la secrétaire du laboratoire Labomac pour plus d’informations via le numéro suivant : +212 522 22 14 95
AMH : l’hormone de la Réserve Ovarienne peut être dosée à n’importe quel jour du cycle, la valeur reste stable et les variations sont insignifiantes tout au long du cycle menstruel
FSH, LH, ESTRADIOL : du 2ème au 4ème jour du cycle menstruel.
Le taux de PROGESTERONE doit être analysée le 21e jour du cycle menstruel.
Veuillez contacter la secrétaire du laboratoire Labomac pour plus d’informations via le numéro suivant : +212 522 22 14 95
Veuillez contacter la secrétaire du centre : via le numéro WhatsApp de notre coordinatrice +212 671945387.
choisissez ci-dessous l’option qui vous convient le plus, ou appelez-nous au:
Conditions pour la réalisation d’un spermogramme :
Abstinence : 2 à 5 jours
Émission : au laboratoire
Méthode : selon l’OMS la masturbation est la méthode de référence, cependant l’émission à domicile est tolérée si l’acheminement a LABOMAC n’excède pas 30 minutes
Précautions : laver les mains et la verge à la savonnette neutre ou autre antiseptique équivalent
Mettre l’intégralité de l’émission dans le flacon fourni par LABOMAC
Veuillez contacter la secrétaire du laboratoire Labomac pour plus d’informations via le numéro suivant : +212 522 22 14 95
AMH : l’hormone de la Réserve Ovarienne peut être dosée à n’importe quel jour du cycle, la valeur reste stable et les variations sont insignifiantes tout au long du cycle menstruel
FSH, LH, ESTRADIOL : du 2ème au 4ème jour du cycle menstruel.
Le taux de PROGESTERONE doit être analysée le 21e jour du cycle menstruel.
Veuillez contacter la secrétaire du laboratoire Labomac pour plus d’informations via le numéro suivant : +212 522 22 14 95
Veuillez contacter la secrétaire du centre : via le numéro WhatsApp de notre coordinatrice +212 671945387.